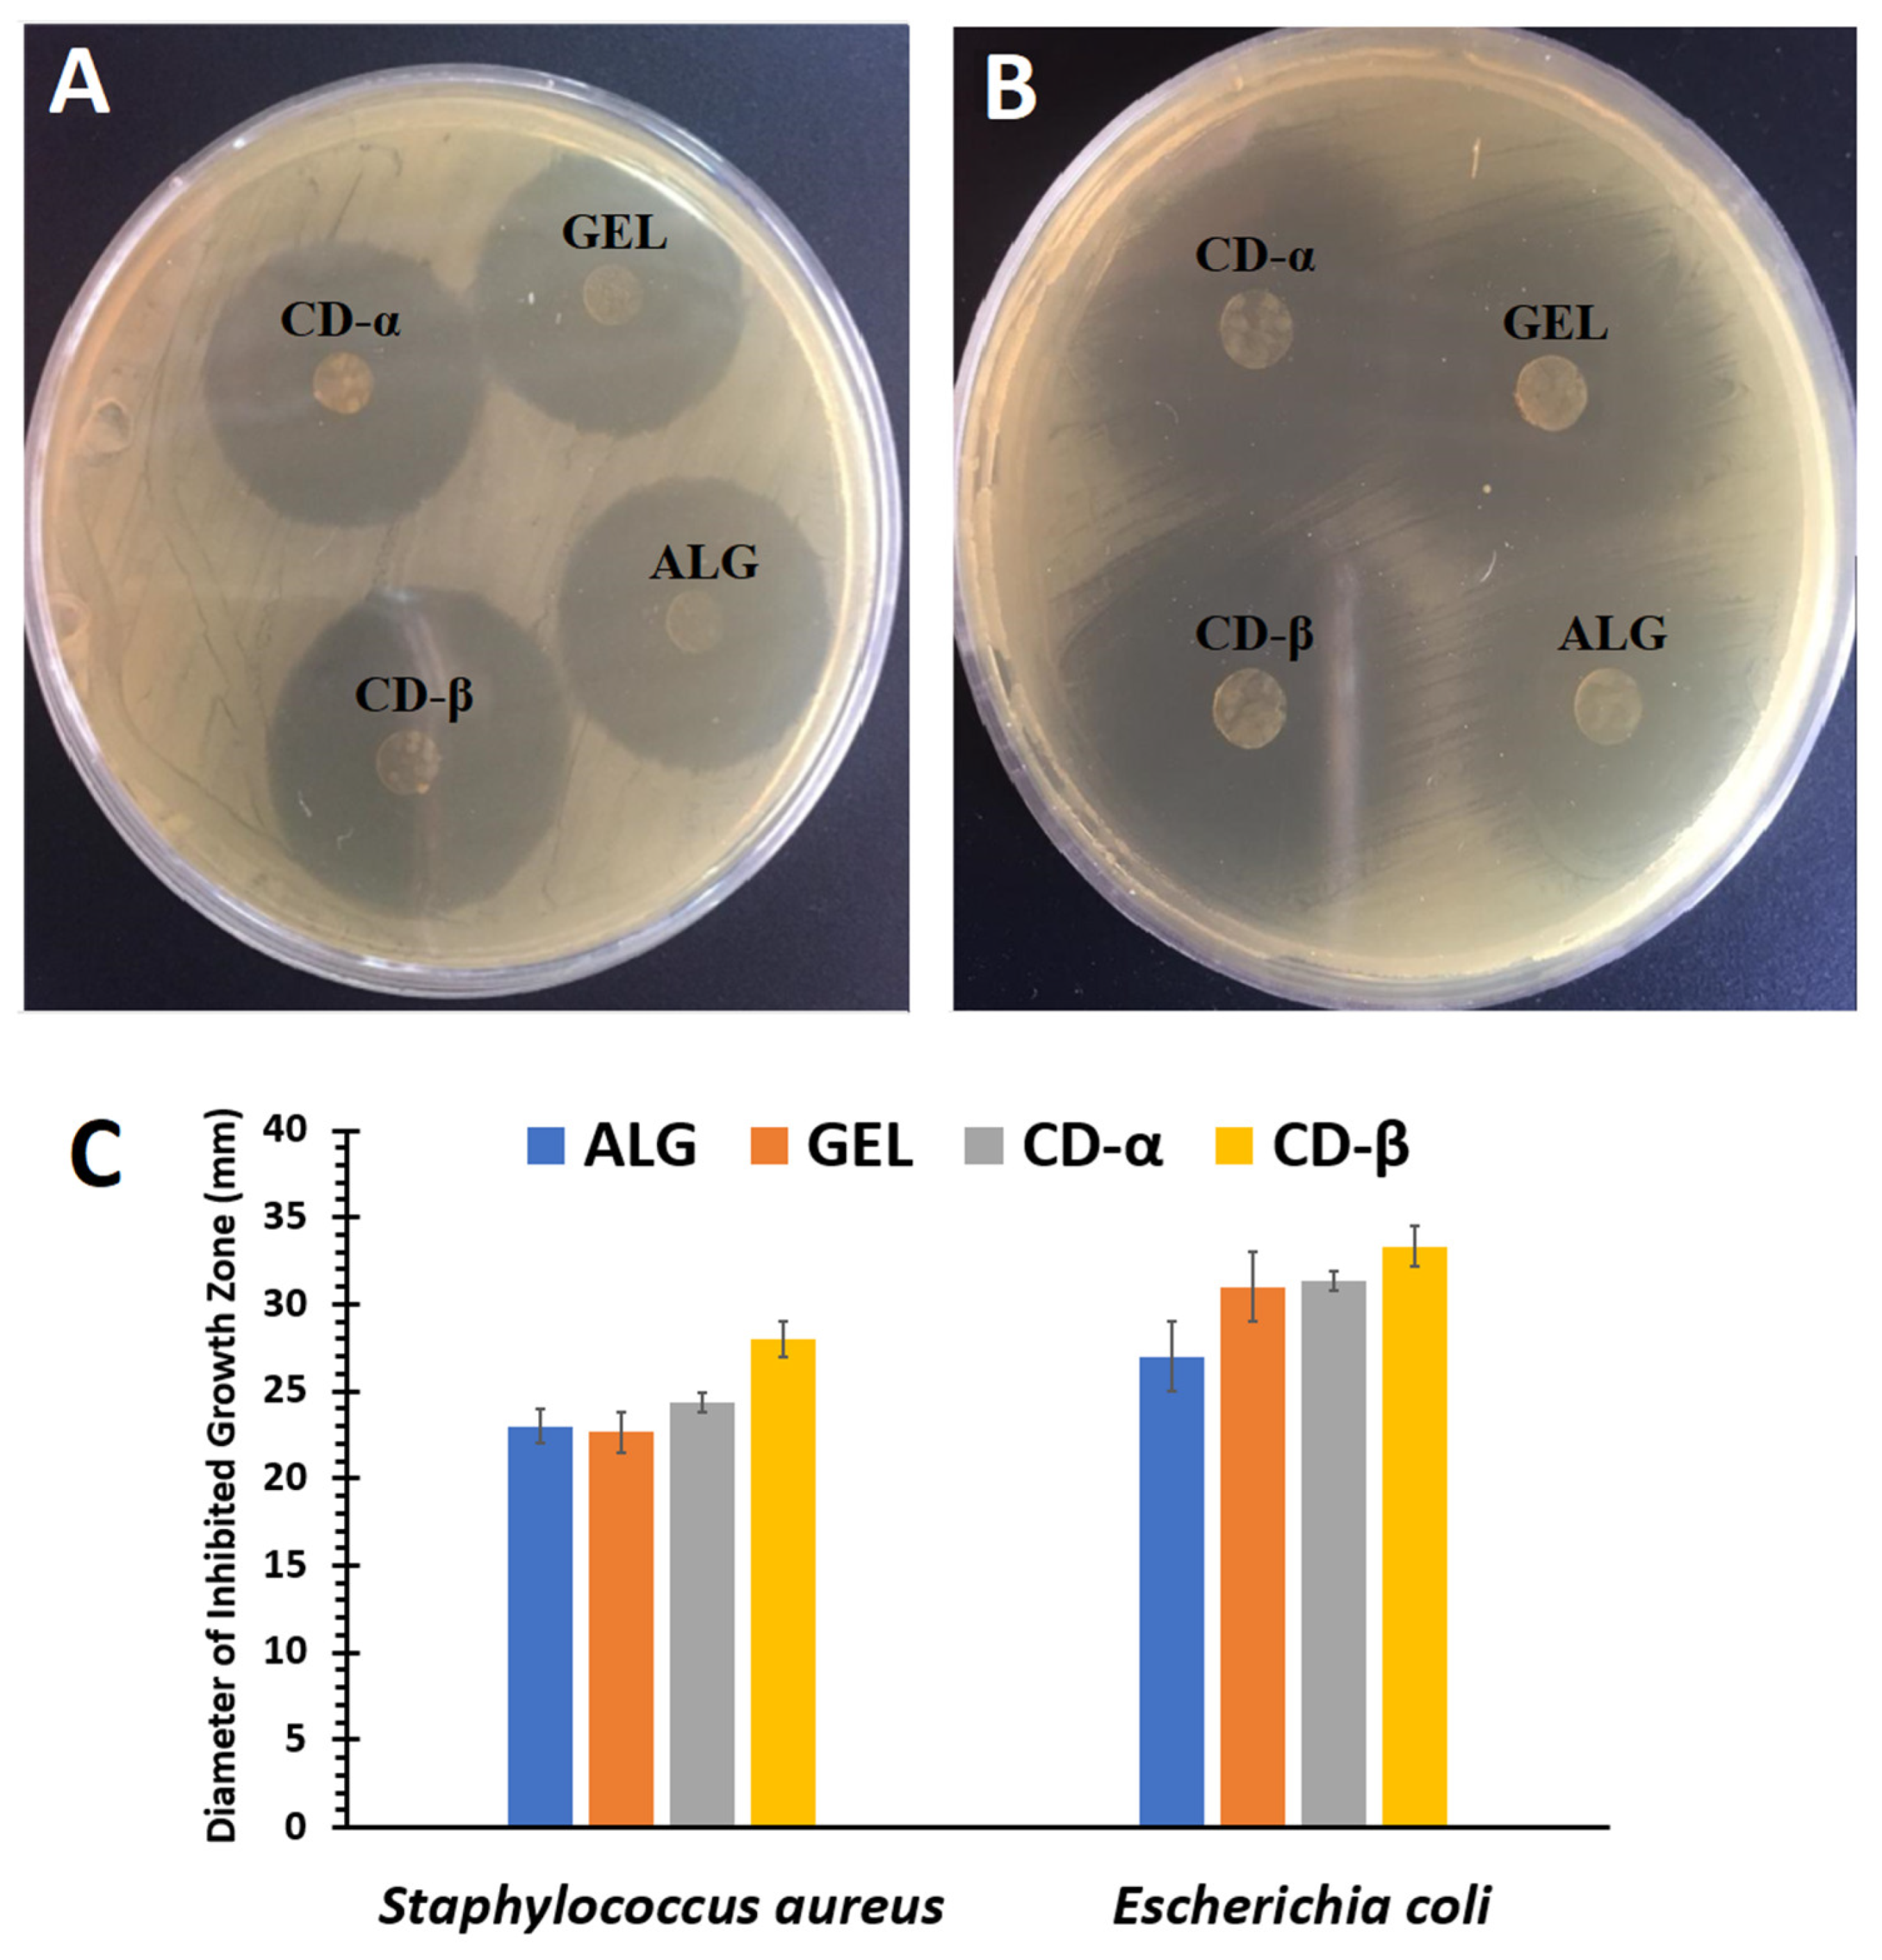

Eudragit® L100/Polyvinyl Alcohol Nanoparticles Impregnated Mucoadhesive Films as Ocular Inserts for Controlled Delivery of Erythromycin: Development, Characterization and In Vivo Evaluation
Abstract
:1. Introduction
2. Materials and Methods
2.1. Materials
2.2. Preparation of ERY-Loaded Nanoparticles
2.3. Preparation of Polymeric Ocular Inserts Containing ERY-Loaded Nanoparticles
2.4. Characterization of ERY-Loaded EUD/PVA Nanoparticles
2.4.1. Lyophilization
2.4.2. Size and Zeta Potential Analysis
2.4.3. Entrapment Efficacy
2.4.4. Drug Loading
2.5. Characterization of Ocular Inserts Containing ERY-Loaded Nanoparticles
2.5.1. Thickness
2.5.2. Folding Endurance
2.5.3. Percentage of Swelling
2.5.4. Moisture Loss and Moisture Uptake
2.5.5. Surface pH
2.5.6. Tensile Strength
2.5.7. Ex Vivo Mucoadhesion Time
2.6. Fourier Transform Infrared Spectroscopy (FTIR)
2.7. Scanning Electron Microscopy (SEM)
2.8. Antibacterial Efficacy
2.9. Microbiological Assay
2.10. In Vitro Release Study
2.11. Sterility Test
2.12. In Vivo Ocular Irritation
2.13. In Vivo Bioavailability Study
2.14. Statistical Analysis
3. Results and Discussion
3.1. Characterization of ERY-Loaded EUD/PVA Nanoparticles
3.2. Characterization of Ocular Inserts
3.3. Fourier Transform Infrared Spectroscopy (FTIR)
3.4. Scanning Electron Microscopy (SEM)
3.5. Antibacterial Efficacy
3.6. Microbiological Assay
3.7. In Vitro Release Study
3.8. Sterility Test
3.9. Irritation Test
3.10. In Vivo Tear Fluid Bioavailability Study
4. Conclusions
Author Contributions
Funding
Institutional Review Board Statement
Informed Consent Statement
Data Availability Statement
Acknowledgments
Conflicts of Interest
References
- Bhattacharjee, A.; Das, P.J.; Adhikari, P.; Marbaniang, D.; Pal, P.; Ray, S.; Mazumder, B. Novel drug delivery systems for ocular therapy: With special reference to liposomal ocular delivery. Eur. J. Ophthalmol. 2019, 29, 113–126. [Google Scholar] [CrossRef]
- Gaudana, R.; Ananthula, H.K.; Parenky, A.; Mitra, A.K. Ocular drug delivery. AAPS J. 2010, 12, 348–360. [Google Scholar] [CrossRef] [PubMed]
- Gilhotra, R.M.; Nagpal, K.; Mishra, D.N. Azithromycin novel drug delivery system for ocular application. Int. J. Pharm. Investig. 2011, 1, 22–28. [Google Scholar] [CrossRef] [PubMed] [Green Version]
- Patel, A.; Cholkar, K.; Agrahari, V.; Mitra, A.K. Ocular drug delivery systems: An overview. World J. Pharmacol. 2013, 2, 47–64. [Google Scholar] [CrossRef] [PubMed]
- Ahuja, A.; Khar, R.K.; Ali, J. Mucoadhesive drug delivery systems. Drug Dev. Ind. Pharm. 1997, 23, 489–515. [Google Scholar] [CrossRef]
- Del Amo, E.M.; Urtti, A. Current and future ophthalmic drug delivery systems. A shift to the posterior segment. Drug Discov. Today 2008, 13, 135–143. [Google Scholar] [CrossRef]
- Le Bourlais, C.; Acar, L.; Zia, H.; Sado, P.A.; Needham, T.; Leverge, R. Ophthalmic drug delivery systems—Recent advances. Prog. Retin. Eye Res. 1998, 17, 33–58. [Google Scholar] [CrossRef]
- Mehrandish, S.; Mirzaeei, S. A Review on Ocular Novel Drug Delivery Systems of Antifungal Drugs: Functional Evaluation and Comparison of Conventional and Novel Dosage Forms. Adv. Pharm. Bull. 2021, 11, 28–38. [Google Scholar] [CrossRef]
- Mirzaeei, S.; Berenjian, K.; Khazaei, R. Preparation of the Potential Ocular Inserts by Electrospinning Method to Achieve the Prolong Release Profile of Triamcinolone Acetonide. Adv. Pharm. Bull. 2018, 8, 21–27. [Google Scholar] [CrossRef]
- Taghe, S.; Mirzaeei, S. Preparation and characterization of novel, mucoadhesive ofloxacin nanoparticles for ocular drug delivery. Braz. J. Pharm. Sci. 2019, 55, e17105. [Google Scholar] [CrossRef] [Green Version]
- Soppimath, K.S.; Aminabhavi, T.M.; Kulkarni, A.R.; Rudzinski, W.E. Biodegradable polymeric nanoparticles as drug delivery devices. J. Control. Release 2001, 70, 1–20. [Google Scholar] [CrossRef]
- Mitchell, M.J.; Billingsley, M.M.; Haley, R.M.; Wechsler, M.E.; Peppas, N.A.; Langer, R. Engineering precision nanoparticles for drug delivery. Nat. Rev. Drug Discov. 2021, 20, 101–124. [Google Scholar] [CrossRef] [PubMed]
- Kumari, A.; Yadav, S.K.; Yadav, S.C. Biodegradable polymeric nanoparticles based drug delivery systems. Colloids Surf. B Biointerfaces 2010, 75, 1–18. [Google Scholar] [CrossRef] [PubMed]
- Nagarwal, R.C.; Kant, S.; Singh, P.N.; Maiti, P.; Pandit, J.K. Polymeric nanoparticulate system: A potential approach for ocular drug delivery. J. Control. Release 2009, 136, 2–13. [Google Scholar] [CrossRef]
- Zhou, H.Y.; Hao, J.L.; Wang, S.; Zheng, Y.; Zhang, W.S. Nanoparticles in the ocular drug delivery. Int. J. Ophthalmol. 2013, 6, 390–396. [Google Scholar] [CrossRef]
- Hermans, K.; Van den Plas, D.; Kerimova, S.; Carleer, R.; Adriaensens, P.; Weyenberg, W.; Ludwig, A. Development and characterization of mucoadhesive chitosan films for ophthalmic delivery of cyclosporine A. Int. J. Pharm. 2014, 472, 10–19. [Google Scholar] [CrossRef]
- Khutoryanskaya, O.V.; Morrison, P.W.; Seilkhanov, S.K.; Mussin, M.N.; Ozhmukhametova, E.K.; Rakhypbekov, T.K.; Khutoryanskiy, V.V. Hydrogen-bonded complexes and blends of poly(acrylic acid) and methylcellulose: Nanoparticles and mucoadhesive films for ocular delivery of riboflavin. Macromol. Biosci. 2014, 14, 225–234. [Google Scholar] [CrossRef] [Green Version]
- Mohammadi, G.; Mirzaeei, S.; Taghe, S.; Mohammadi, P. Preparation and Evaluation of Eudragit® L100 Nanoparticles Loaded Impregnated with KT Tromethamine Loaded PVA-HEC Insertions for Ophthalmic Drug Delivery. Adv. Pharm. Bull. 2019, 9, 593–600. [Google Scholar] [CrossRef]
- Querengesser, E.I.; Ormsby, H.L. Ocular penetration of erythromycin. Can. Med. Assoc. J. 1955, 72, 200–202. [Google Scholar]
- Naib, K.; Hallett, J.W.; Leopold, I.H. Observations on the ocular effects of erythromycin. Am. J. Ophthalmol. 1955, 39, 395–399. [Google Scholar] [CrossRef]
- Freidlin, J.; Acharya, N.; Lietman, T.M.; Cevallos, V.; Whitcher, J.P.; Margolis, T.P. Spectrum of eye disease caused by methicillin-resistant Staphylococcus aureus. Am. J. Ophthalmol. 2007, 144, 313–315. [Google Scholar] [CrossRef] [PubMed]
- Hammerschlag, M.R.; Chandler, J.W.; Alexander, E.R.; English, M.; Chiang, W.T.; Koutsky, L.; Eschenbach, D.A.; Smith, J.R. Erythromycin ointment for ocular prophylaxis of neonatal chlamydial infection. JAMA 1980, 244, 2291–2293. [Google Scholar] [CrossRef] [PubMed]
- Robert, P.Y.; Adenis, J.P. Comparative review of topical ophthalmic antibacterial preparations. Drugs 2001, 61, 175–185. [Google Scholar] [CrossRef] [PubMed]
- Zafar, A.; Imam, S.S.; Yasir, M.; Alruwaili, N.K.; Alsaidan, O.A.; Warsi, M.H.; Mir Najib Ullah, S.N.; Alshehri, S.; Ghoneim, M.M. Preparation of NLCs-Based Topical Erythromycin Gel: In Vitro Characterization and Antibacterial Assessment. Gels 2022, 8, 116. [Google Scholar] [CrossRef] [PubMed]
- Verma, D.; Kaul, S.; Jain, N.; Nagaich, U. Fabrication and characterization of ocular phase transition systems for blepharitis: A novel approach. Drug Deliv. Lett. 2020, 10, 24–37. [Google Scholar] [CrossRef]
- Rasheed, S.H.; Samanvitha, M.; Manjunath, S. Formulation and in-vitro characterization of erythromycin ocular inserts. Int. J. Res. Pharm. Sci. Tech. 2020, 2, 44–50. [Google Scholar] [CrossRef]
- Bodmeier, R.; Chen, H.; Tyle, P.; Jarosz, P. Spontaneous formation of drug-containing acrylic nanoparticles. J. Microencapsul. 1991, 8, 161–170. [Google Scholar] [CrossRef]
- Taghe, S.; Mirzaeei, S.; Alany, R.G.; Nokhodchi, A. Polymeric inserts containing Eudragit® L100 nanoparticle for improved ocular delivery of azithromycin. Biomedicines 2020, 8, 466. [Google Scholar] [CrossRef]
- Mehrandish, S.; Mohammadi, G.; Mirzaeei, S. Preparation and functional evaluation of electrospun polymeric nanofibers as a new system for sustained topical ocular delivery of itraconazole. Pharm. Dev. Technol. 2022, 27, 25–39. [Google Scholar] [CrossRef]
- Tofighia, P.; Soltani, S.; Montazam, S.H.; Montazam, S.A.; Jelvehgari, M. Formulation of tolmetin ocuserts as carriers for ocular drug delivery system. Iran. J. Pharm. Res. 2017, 16, 432–441. [Google Scholar]
- Mustafa, W.W.; Fletcher, J.; Khoder, M.; Alany, R.G. Solid Dispersions of Gefitinib Prepared by Spray Drying with Improved Mucoadhesive and Drug Dissolution Properties. AAPS PharmSciTech 2022, 4, 48. [Google Scholar] [CrossRef] [PubMed]
- Thrimawithana, T.R.; Young, A.; Buntac, C.R.; Greend, C.R.; Alany, R.G. In-vitro and in-vivo evaluation of carrageenan/methylcellulose polymeric systems for transscleral delivery of macromolecules. Eur. J. Pharm. Sci. 2011, 44, 399–409. [Google Scholar] [CrossRef]
- Sabbagh, F.; Kiarostami, K.; Mahmoudi Khatir, N.; Rezania, S.; Muhamad, I.I. Green Synthesis of Mg0.99 Zn0.01O Nanoparticles for the Fabrication of κ-Carrageenan/NaCMC Hydrogel in order to Deliver Catechin. Polymers 2020, 12, 861. [Google Scholar] [CrossRef] [PubMed] [Green Version]
- Rattanapoltaveechai, R.; Vongkom, W.; Suntornsuk, W.; Suntornsuk, L. Simple and rapid spectrophotometric method for the analysis of erythromycin in pharmaceutical dosage forms. J. Food Drug Anal. 2007, 15, 10–14. [Google Scholar] [CrossRef]
- Griessmann, K.; Kaunzinger, A.; Schubert-Zsilavecz, M.; Abdel-Tawab, M. A rapid HPLC-UV method for the quantification of erythromycin in dermatological preparations. Pharmazie 2007, 62, 668–671. [Google Scholar]
- Queiroz, K.M.; Silva, M.-L.M.; Prado, N.D.; Lima, P.M.A.; Diniz, R.D.L.; César, I.C.; Pianetti, G.A.; Santos, D.A. Comparison of microbiological assay and HPLC-UV for determination of fluconazole in capsules. Braz. J. Pharm. Sci. 2009, 45, 693–700. [Google Scholar] [CrossRef]
- Bahrami, G.; Mirzaeei, S.; Kiani, A. High performance liquid chromatographic determination of azithromycin in serum using fluorescence detection and its application in human pharmacokinetic studies. J. Chromatogr. B 2005, 820, 277–281. [Google Scholar] [CrossRef] [PubMed]
- Cháfer-Pericás, C.; Maquieira, Á.; Puchades, R. Fast screening methods to detect antibiotic residues in food samples. Trends Anal. Chem. 2010, 29, 1038–1049. [Google Scholar] [CrossRef]
- Diebold, Y.; Jarrín, M.; Sáez, V.; Carvalho, E.L.; Orea, M.; Calonge, M.; Seijo, B.; Alonso, M.J. Ocular drug delivery by liposome–chitosan nanoparticle complexes (LCS-NP). Biomaterials 2007, 28, 1553–1564. [Google Scholar] [CrossRef]
- Schopf, L.R.; Popov, A.M.; Enlow, E.M.; Bourassa, J.L.; Ong, W.Z.; Nowak, P.; Chen, H. Topical ocular drug delivery to the back of the eye by mucus-penetrating particles. Transl. Vis. Sci. Technol. 2015, 4, 11. [Google Scholar] [CrossRef] [Green Version]
- Gagandeep; Garg, T.; Malik, B.; Rath, G.; Goyal, A.K. Development and characterization of nano-fiber patch for the treatment of glaucoma. Eur. J. Pharm. Sci. 2014, 53, 10–16. [Google Scholar] [CrossRef] [PubMed]
- Sun, X.; Yu, Z.; Cai, Z.; Yu, L.; Lv, Y. Voriconazole composited polyvinyl alcohol/hydroxypropyl-β-cyclodextrin nanofibers for ophthalmic delivery. PLoS ONE 2016, 11, e0167961. [Google Scholar] [CrossRef] [PubMed]
- Hao, S.; Wang, B.; Wang, Y.; Zhu, L.; Wang, B.; Guo, T. Preparation of Eudragit L 100-55 enteric nanoparticles by a novel emulsion diffusion method. Colloids Surf. B Biointerfaces 2013, 108, 127–133. [Google Scholar] [CrossRef]
- Cetin, M.; Atila, A.; Kadioglu, Y. Formulation and in vitro characterization of Eudragit® L100 and Eudragit® L100-PLGA nanoparticles containing diclofenac sodium. AAPS PharmSciTech 2010, 11, 1250–1256. [Google Scholar] [CrossRef] [Green Version]
- Tuncay, M.; Calis, S.; Kas, H.S.; Ercan, M.T.; Peksoy, I.; Hincal, A.A. Diclofenac sodium incorporated PLGA (50:50) microspheres: Formulation considerations and in vitro/in vivo evaluation. Int. J. Pharm. 2000, 195, 179–188. [Google Scholar] [CrossRef]
- Terreni, E.; Chetoni, P.; Burgalassi, S.; Tampucci, S.; Zucchetti, E.; Chipala, E.; Alany, R.G.; Al-Kinani, A.A.; Monti, D. A hybrid ocular delivery system of cyclosporine-A comprising nanomicelle-laden polymeric inserts with improved efficacy and tolerability. Biomater. Sci. 2021, 9, 8235–8248. [Google Scholar] [CrossRef]
- Glasser, W.G. 6. Prospects for future applications of cellulose acetate. In Proceedings of the Macromolecular Symposia, Weinheim, Germany, 21 April 2004; pp. 371–394. [Google Scholar]
- Zong, X.; Kim, K.; Fang, D.; Ran, S.; Hsiao, B.S.; Chu, B. Structure and process relationship of electrospun bioabsorbable nanofiber membranes. Polymer 2002, 43, 4403–4412. [Google Scholar] [CrossRef]
- Kumari, A.; Sharma, P.K.; Garg, V.K.; Garg, G. Ocular inserts—Advancement in therapy of eye diseases. J. Adv. Pharm. Technol. Res. 2010, 1, 291–296. [Google Scholar] [CrossRef] [Green Version]
- Bodor, N.; Buchwald, P. Ophthalmic drug design based on the metabolic activity of the eye: Soft drugs and chemical delivery systems. AAPS J. 2005, 7, E820–E833. [Google Scholar] [CrossRef] [Green Version]
- Mishra, D.; Gilhotra, R. Design and characterization of bioadhesive in-situ gelling ocular inserts of gatifloxacin sesquihydrate. DARU J. Pharm. Sci. 2008, 16, 1–8. [Google Scholar]
- Sharma, S.; Mohanty, S.; Gupta, D.; Jassal, M.; Agrawal, A.K.; Tandon, R. Cellular response of limbal epithelial cells on electrospun poly-epsilon-caprolactone nanofibrous scaffolds for ocular surface bioengineering: A preliminary in vitro study. Mol. Vis. 2011, 17, 2898–2910. [Google Scholar]
- Parveen, S.; Chaudhury, P.; Dasmahapatra, U.; Dasgupta, S. Biodegradable protein films from gallic acid and the cataractous eye protein isolate. Int. J. Biol. Macromol. 2019, 139, 12–20. [Google Scholar] [CrossRef] [PubMed]
- Tanwar, Y.; Patel, D.; Sisodia, S. In vitro and in vivo evaluation of ocular inserts of ofloxacin. DARU J. Pharm. Sci. 2007, 15, 139–145. [Google Scholar]
- Wibowo, A.C.; Misra, M.; Park, H.-M.; Drzal, L.T.; Schalek, R.; Mohanty, A.K. Biodegradable nanocomposites from cellulose acetate: Mechanical, morphological, and thermal properties. Compos. Part A Appl. Sci. Manuf. 2006, 37, 1428–1433. [Google Scholar] [CrossRef]
- Anirudhan, T.S.; Mohan, A.M. Novel pH sensitive dual drug loaded-gelatin methacrylate/methacrylic acid hydrogel for the controlled release of antibiotics. Int. J. Biol. Macromol. 2018, 110, 167–178. [Google Scholar] [CrossRef] [PubMed]
- Rathod, L.V.; Kapadia, R.; Sawant, K.K. A novel nanoparticles impregnated ocular insert for enhanced bioavailability to posterior segment of eye: In vitro, in vivo and stability studies. Mater. Sci. Eng. C Mater. Biol. Appl. 2017, 71, 529–540. [Google Scholar] [CrossRef]
- Adhikari, R.P.; Shrestha, S.; Barakoti, A.; Amatya, R. Inducible clindamycin and methicillin resistant Staphylococcus aureus in a tertiary care hospital, Kathmandu, Nepal. BMC Infect. Dis. 2017, 17, 483. [Google Scholar] [CrossRef]
- Tereshchenkov, A.; Shishkina, A.; Karpenko, V.; Chertkov, V.; Konevega, A.; Kasatsky, P.; Bogdanov, A.; Sumbatyan, N. New fluorescent macrolide derivatives for studying interactions of antibiotics and their analogs with the ribosomal exit tunnel. Biochemistry 2016, 81, 1163–1172. [Google Scholar] [CrossRef] [PubMed]
- Hedges, A. Cyclodextrins: Properties and applications. In Starch; Elsevier: Amsterdam, The Netherlands, 2009; pp. 833–851. [Google Scholar]
- Gokce, E.H.; Sandri, G.; Bonferoni, M.C.; Rossi, S.; Ferrari, F.; Güneri, T.; Caramella, C. Cyclosporine A loaded SLNs: Evaluation of cellular uptake and corneal cytotoxicity. Int. J. Pharm. 2008, 364, 76–86. [Google Scholar] [CrossRef]
- Driot, J.-Y.; Novack, G.D.; Rittenhouse, K.D.; Milazzo, C.; Pearson, A.P. Ocular pharmacokinetics of fluocinolone acetonide after Retisert™ intravitreal implantation in rabbits over a 1-year period. J. Ocul. Pharmacol. Ther. 2004, 20, 269–275. [Google Scholar] [CrossRef]
- Ghate, D.; Edelhauser, H.F. Ocular drug delivery. Expert Opin. Drug Deliv. 2006, 3, 275–287. [Google Scholar] [CrossRef] [PubMed]
- Chhonker, Y.S.; Prasad, Y.D.; Chandasana, H.; Vishvkarma, A.; Mitra, K.; Shukla, P.K.; Bhatta, R.S. Amphotericin-B entrapped lecithin/chitosan nanoparticles for prolonged ocular application. Int. J. Biol. Macromol. 2015, 72, 1451–1458. [Google Scholar] [CrossRef] [PubMed]
- Mirzaeei, S.; Taghe, S.; Asare-Addo, K.; Nokhodchi, A. Polyvinyl Alcohol/Chitosan Single-Layered and Polyvinyl Alcohol/Chitosan/Eudragit RL100 Multi-layered Electrospun Nanofibers as an Ocular Matrix for the Controlled Release of Ofloxacin: An In Vitro and In Vivo Evaluation. AAPS PharmSciTech 2021, 22, 170. [Google Scholar] [CrossRef] [PubMed]

| Formulation | Particle Size (nm) | Polydispersity Index | Zeta Potential (mV) | DL (%) | EE (%) |
|---|---|---|---|---|---|
| Nanoparticles | 66.44 ± 4.19 | 0.40 ± 0.03 | −6.03 ± 2.34 | 22.41 ± 2.55 | 50.71 ± 3.16 |
| Parameter | Formulations | ||||
|---|---|---|---|---|---|
| ALG | GEL | CD-α | CD-β | ||
| Weight (mg) | 20.19 ± 0.65 | 23.61 ± 0.25 | 22.14 ± 0.20 | 21.63 ± 0.30 | |
| Thickness (mm) | 0.148 ± 0.004 | 0.172 ± 0.002 | 0.170 ± 0.006 | 0.155 ± 0.003 | |
| Folding endurance (times) | 227.0 ± 5.2 | 355.3 ± 6.1 | 341.0 ± 8.5 | 303.1 ± 8.1 | |
| pH | 6.64 ± 0.03 | 6.69 ± 0.02 | 6.50 ± 0.02 | 6.52 ± 0.04 | |
| Tensile Strength (MPa) | 2.10 ± 0.01 | 3.42 ± 0.01 | 2.35 ± 0.07 | 2.30 ± 0.01 | |
| Swelling (%) | 30 min | 55.3 ± 0.8 | 101.0 ± 1.9 | 74.3 ± 0.4 | 80.3 ± 1.9 |
| 60 min | 91.2 ± 0.8 | 189.0 ± 3.6 | 154.0 ± 3.6 | 175.0 ± 0.4 | |
| 120 min | 147.3 ± 0.8 | 194.0 ± 1.9 | 174.3 ± 1.9 | 181.0 ± 0.4 | |
| Moisture uptake (%) | 0.77 ± 0.07 | 2.08 ± 0.09 | 1.62 ± 0.08 | 0.88 ± 0.13 | |
| Moisture loss (%) | 1.16 ± 0.05 | 1.60 ± 0.07 | 0.51 ± 0.08 | 0.97 ± 0.13 | |
| Mucoadhesion time (min) | 8.4 ± 0.4 | 9.2 ± 0.2 | 9.4 ± 0.3 | 10.7 ± 0.5 | |
| Concentration of ERY (μg/mL) | Accuracy (%) | Precision (CV %) | ||
|---|---|---|---|---|
| Intra-Day | Inter-Day | Intra-Day | Inter-Day | |
| 125 | 102.947 | 112.268 | 0.494 | 0.703 |
| 62.5 | 94.581 | 114.266 | 0.401 | 0.477 |
| 31.25 | 116.908 | 110.410 | 0.418 | 0.520 |
| Formulation | Correlation Coefficient (R2) | |||
|---|---|---|---|---|
| Zero-Order | First-Order | Higuchi | Korsemeyer-Peppas | |
| ALG | 0.9030 | 0.9341 | 0.9847 | 0.9606 |
| GEL | 0.9400 | 0.9595 | 0.9898 | 0.9572 |
| CD-α | 0.9096 | 0.9614 | 0.9858 | 0.9465 |
| CD-β | 0.9325 | 0.9579 | 0.9839 | 0.9837 |
| Formulation | Time (h) | Cornea | Iris | Conjunctivae | Total Score | |||
|---|---|---|---|---|---|---|---|---|
| Opacity | Area of Cornea Involved | Interruption for Reaction to Light | Redness | Chemosis | Discharge | |||
| Control | 24 | 0 | 0 | 0 | 0 | 0 | 0 | 0 |
| 48 | 0 | 0 | 0 | 0 | 0 | 0 | 0 | |
| 72 | 0 | 0 | 0 | 0 | 0 | 0 | 0 | |
| ALG | 24 | 0 | 0 | 0 | 1 | 0 | 0 | 1 |
| 48 | 0 | 0 | 0 | 0 | 0 | 0 | 0 | |
| 72 | 0 | 0 | 0 | 0 | 0 | 0 | 0 | |
| GEL | 24 | 0 | 0 | 0 | 0 | 0 | 0 | 0 |
| 48 | 0 | 0 | 0 | 0 | 0 | 0 | 0 | |
| 72 | 0 | 0 | 0 | 0 | 0 | 0 | 0 | |
| CD-α | 24 | 0 | 0 | 0 | 0 | 0 | 0 | 0 |
| 48 | 0 | 0 | 0 | 0 | 0 | 0 | 0 | |
| 72 | 0 | 0 | 0 | 0 | 0 | 0 | 0 | |
| CD-β | 24 | 0 | 0 | 0 | 0 | 0 | 0 | 0 |
| 48 | 0 | 0 | 0 | 0 | 0 | 0 | 0 | |
| 72 | 0 | 0 | 0 | 0 | 0 | 0 | 0 | |
| Formulation | CMax (μg/mL) | AUC0–120 (μg·h/mL) | MRT (h) |
|---|---|---|---|
| Ointment | 1309.91 ± 260.90 | 4986.62 ± 630.85 | 3.67 ± 0.16 |
| ALG | 2945.43 ± 196.72 | 30,020.92 ± 45.54 | 24.85 ± 0.01 |
| GEL | 2990.35 ± 133.20 | 33,917.77 ± 3023.76 | 21.91 ± 0.10 |
| CD-α | 1845.21 ± 286.60 | 32,786.23 ± 3550.15 | 21.60 ± 0.48 |
| CD-β | 2640.18 ± 234.97 | 35,938.29 ± 602.54 | 28.27 ± 0.14 |
Publisher’s Note: MDPI stays neutral with regard to jurisdictional claims in published maps and institutional affiliations. |
© 2022 by the authors. Licensee MDPI, Basel, Switzerland. This article is an open access article distributed under the terms and conditions of the Creative Commons Attribution (CC BY) license (https://creativecommons.org/licenses/by/4.0/).
Share and Cite
Mirzaeei, S.; Taghe, S.; Alany, R.G.; Nokhodchi, A. Eudragit® L100/Polyvinyl Alcohol Nanoparticles Impregnated Mucoadhesive Films as Ocular Inserts for Controlled Delivery of Erythromycin: Development, Characterization and In Vivo Evaluation. Biomedicines 2022, 10, 1917. https://doi.org/10.3390/biomedicines10081917
Mirzaeei S, Taghe S, Alany RG, Nokhodchi A. Eudragit® L100/Polyvinyl Alcohol Nanoparticles Impregnated Mucoadhesive Films as Ocular Inserts for Controlled Delivery of Erythromycin: Development, Characterization and In Vivo Evaluation. Biomedicines. 2022; 10(8):1917. https://doi.org/10.3390/biomedicines10081917
Chicago/Turabian StyleMirzaeei, Shahla, Shiva Taghe, Raid G. Alany, and Ali Nokhodchi. 2022. "Eudragit® L100/Polyvinyl Alcohol Nanoparticles Impregnated Mucoadhesive Films as Ocular Inserts for Controlled Delivery of Erythromycin: Development, Characterization and In Vivo Evaluation" Biomedicines 10, no. 8: 1917. https://doi.org/10.3390/biomedicines10081917
APA StyleMirzaeei, S., Taghe, S., Alany, R. G., & Nokhodchi, A. (2022). Eudragit® L100/Polyvinyl Alcohol Nanoparticles Impregnated Mucoadhesive Films as Ocular Inserts for Controlled Delivery of Erythromycin: Development, Characterization and In Vivo Evaluation. Biomedicines, 10(8), 1917. https://doi.org/10.3390/biomedicines10081917

